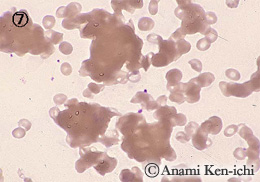
7

血球計数装置における阻害因子にあげられるものです。
                  対処法として、DFは37℃にて10分ほど加温後に測定し、Gは輸液挿入部位と反対側で採血します。
![]()  | 
                      ![]()  | 
                    
| 血小板類似物質(クリオグロブリン)の出現にて計数装置では血小板や白血球としてカウントされ偽性の増加を呈します。クリオグロブリン血症(IgM増量)の検体を冷蔵庫に保存した場合に出現することがあります。 | 白血球同士のかたまりです。本例はMDSで偽ペルゲル核異常の好中球が集合したものです。 偽性白血球減少症を呈しますが、原因は不明です。  | 
                    
![]()  | 
                      ![]()  | 
                    
| 赤血球同士の凝集です。寒冷凝集などが関与していると考えられ、MCV、MCHCの高値を伴います。37℃で加温後再検します。 | 高カロリー輸液療法(IVH)よりの採血でみられた真菌汚染であり、輸液挿入部分に真菌の感染が発生したものと思われます。胞子状のものは血小板にカウントされやすい。 |